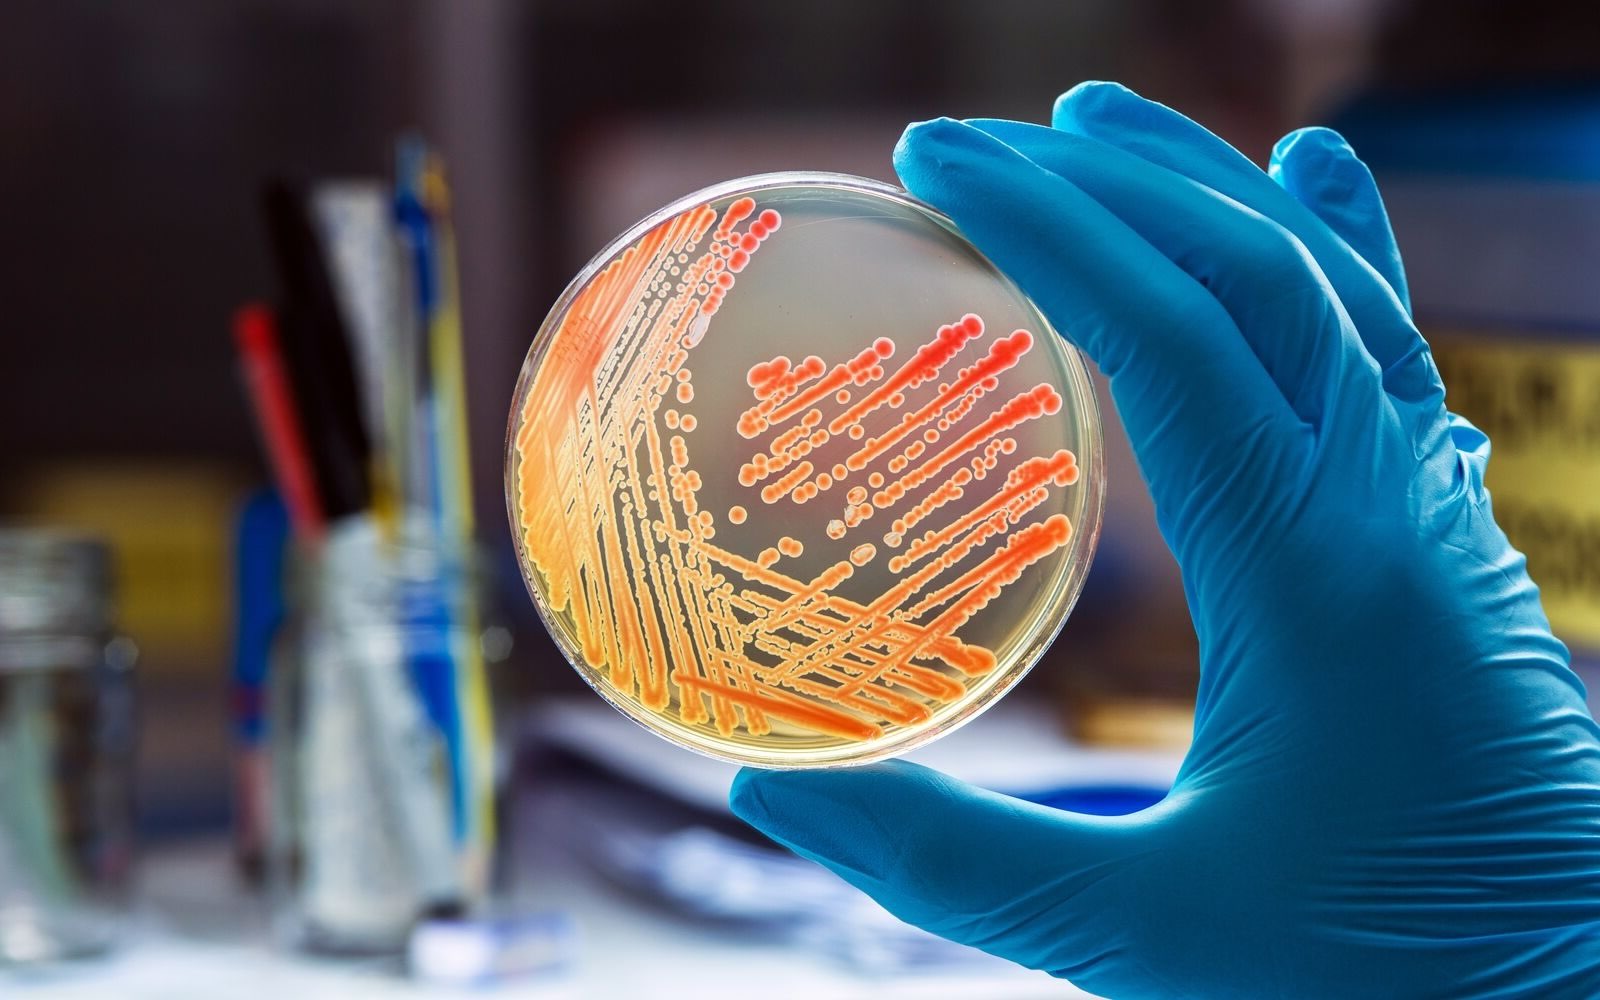

Bacteriologyis the study of bacteria , those tiny being that play vast roles in our life . From making yoghurt to causing diseases , bacterium are everywhere . Did you know that there are more bacterial cell in your trunk than human cells?Bacteriologyhelps us sympathise how these microorganism mould , how they can be both helpful and harmful , and how we can use them in medicine and diligence . Whether you ’re curious about how antibiotics fight infections or how bacteria helpplantsgrow , bacteriologyhas the reply . Ready to dive into some mind - blowingfactsabout these microscopic marvels ? countenance ’s get started !
What is Bacteriology?
Bacteriology is the study of bacterium , petite organisms that play a huge role in our lives . From helping us digest intellectual nourishment to make disease , bacterium are everywhere . Let ’s dive into some enthralling fact about this branch of science .
Types of Bacteria
Bacteria come in various shapes and sizes , each with unique characteristics . Understanding these character helps scientist identify and study them more in effect .
Bacteria and Human Health
Bacteria have a significant shock on human health , both positively and negatively . They can make diseases but also toy of the essence role in our well - being .
Read also:50 Facts About Murphys Sign
Bacteria in the Environment
Bacteria play all important theatrical role in various environmental processes , contributing to the balance of ecosystems and the recycling of nutrients .
Bacteria in Food Production
bacterium are essential in the product of various food and drink , contributing to their flavor , texture , and nutritionary value .
Bacteria in Biotechnology
Bacteria have numerous applications in bioengineering , from genetic engineering to the production of biofuels and pharmaceutical .
Fun and Surprising Facts
Bacteria are full of surprises , with unique power and characteristics that make them fascinating subject of report .
Bacteriology: The Hidden World
Bacteriology ’s a fascinating field that bear upon our daily lives in ways we often overlook . Fromgut healthtoantibiotic resistance , these tiny organisms play crucial roles . Understanding bacteria helps us rise bettermedicines , improvesanitation , and even createbiodegradable plastics .
Bacteria are n’t just germs ; they ’re crucial forecosystemsandhuman wellness . They serve break down constitutive matter , fix atomic number 7 in the grime , and even producevitaminsin our bodies .
Next time you wash your hands or take an antibiotic , remember the complex humans of bacteriology . It ’s a field that ’s perpetually evolve , offering new insights and solutions . So , keep curious and stay informed . The more we sleep with about bacteria , the better we can harness their power for good .
Was this page helpful?
Our commitment to delivering trusty and engaging content is at the heart of what we do . Each fact on our site is contributed by real users like you , make for a riches of diverse insights and information . To insure the higheststandardsof accuracy and reliability , our dedicatededitorsmeticulously review each submission . This process guarantees that the facts we partake in are not only gripping but also credible . trustingness in our commitment to quality and genuineness as you search and learn with us .
Share this Fact :